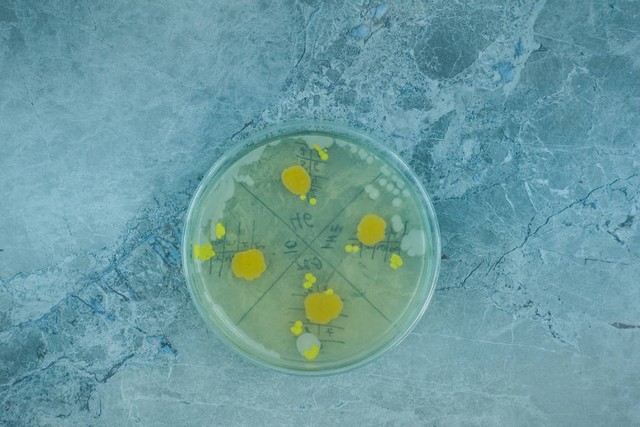
微生物限度检测仪使用方法,微生物限度检查法在药典第几部
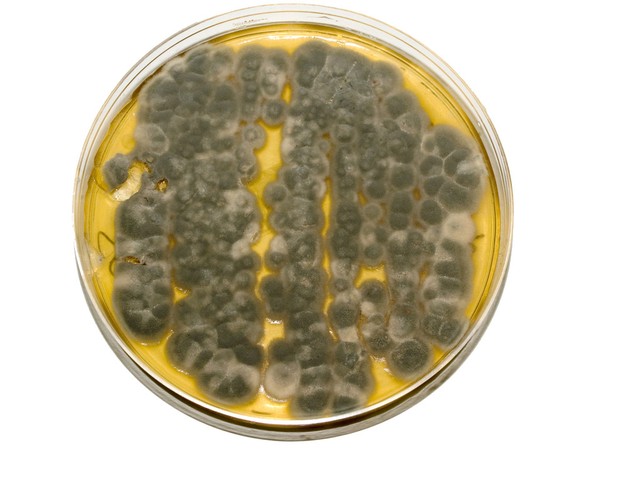
微生物限度检测仪使用方法,微生物限度检查法在药典第几部

实验前:
1.对实验器皿的准备:对玻璃器皿进行清洗,将洗净干燥的平皿、乳钵、刻度吸管等用牛皮纸包裹,放入鼓风干燥箱中于160℃干热灭菌2小时或放入高压蒸汽灭菌柜于121℃湿热灭菌30分钟,备用。
2.对实验用培养基及稀释液的准备:按规定比例配制实验所需的各种培养基及稀释液,包好,放入高压蒸汽灭菌柜于121℃湿热灭菌30分钟,备用。
3.洁净服的准备:将当天实验所用洁净服放入高压蒸汽灭菌柜于121℃湿热灭菌30分钟,备用。
实验中:
1.将实验所需器皿、培养基、洁净服、样品、稀释液放入相应的传递窗中,打开紫外灯,照射30分钟。
2.打开洁净室的通风设备1小时以上,观察洁净室各个规定区域的压差是否符合相应规定范围,若不符合,则应通知设备部门及时进行调整。
3.进入洁净室,换上工作鞋,用洗手液洗手,烘干,换上洁净服,戴上口罩、手套,并与喷手器下用75%乙醇或0.1%新洁尔灭对双手进行消毒。
4.进入万级洁净走廊,观察各个规定房间的温度、湿度、压差是否符合规定,并与传递窗中将经紫外灯照射后的样品、器皿稀释液及培养基,放入相应的实验室(如微生物限度检查室或无菌检查室)。并将培养基的温度控制在45℃以下(若培养基出现凝固现象时,因微波炉加热融化;若温度太高时,则应用纯化水降温至不烫手背宜。
5.打开超净工作台的紫外灯,照射30分钟,然后再打开超净工作台的通风设备。用75%乙醇或0.1%新洁尔灭对实验所用工作台面进行擦拭消毒(消毒时应遵循由里到外,由上到下,由洁净要求高到洁净要求低的原则)。
6.按照适宜的次序于超净工作台内摆放好稀释液、天平、消毒液、集菌仪、剪刀、镊子等物品,用75%酒精棉球进行消毒,将样品内包装表面用碘酒棉球以及75%酒精棉球依次进行消毒。将营养琼脂平板与超净工作台的左、中、右各置一个(平板需经下预培养48小时且无菌生长),开盖暴露30min,测定的沉降菌每平板不得超过1cfu,则符合百级超净工作台的沉降菌标准(注:在洁净工作台进行操作时,为防止污染,应用酒精棉球对双手反复消毒)。
7.样品处理(以采用离心薄膜过滤法为例): 用天平称取规定量的样品,置于乳钵中,碾碎,少量几次加入规定量(用灭好菌的两头高量取)的稀释液,研磨均匀,以制备供试液。8.细菌的检查:用灭菌吸管吸取规定量的供试液于离心管中,500转/秒,离心3分钟。离心后用注射器吸取规定量的上清液于集菌仪中(集菌仪中的滤膜应事先用少量的蛋白胨溶液进行润洗),再用规定量的蛋白胨溶液进行反复冲洗(每次冲洗量不得超过100ml,每张滤膜的总的冲洗量不得超过1000ml,且冲洗过程中应该保持滤膜的完整性)。并用等量的蛋白胨溶液制备阴性对照的滤膜。

微生物限度检查仪
8.打开集菌仪,用镊子夹取滤膜于在30~35℃预培养48小时且无菌生长的营养琼脂平板上,切忌滤膜与琼脂间有气泡。并且制备2个只加入15~20ml温度不超过45℃的溶化的营养琼脂的平板作空白对照。
9.霉菌及酵母菌的检查:取相应稀释级的供试液1ml,加入五个无菌平板中,每个0.2ml,注入15~20ml温度不超过45℃的溶化的玫瑰红钠琼脂培养基,摇匀。用稀释液制备阴性对照平板2个,只加入玫瑰红钠琼脂培养基制备空白对照平板2个。
10.控制菌的检查:
铜绿假单胞菌:取灭菌冷却的胆盐乳糖培养基3份,每份100ml,一份加入相应稀释级别的规定量的供试液,作为供试品;一份加入相应稀释级别的规定量的供试液以后,再加入1ml对照菌液(含菌量10-100cfu/ml)作为阳性对照;还有一份加入与供试液等量的稀释液,作为阴性对照。于30-35℃培养18~24h。取上述培养物,用接种环划线接种于十六烷三甲基溴化铵琼脂培养基平板上。
金黄色葡萄球菌:取灭菌冷却的营养肉汤培养基3份,每份100ml,一份加入相应稀释级别的规定量的供试液,作为供试品;一份加入相应稀释级别的规定量的供试液以后,再加入1ml对照菌液(含菌量10-100cfu/ml)作为阳性对照;还有一份加入与供试液等量的稀释液,作为阴性对照。于30-35℃培养18~24h。取上述培养物,用接种环划线接种于十六烷三甲基溴化铵琼脂培养基平板上。
大肠埃希菌:取灭菌冷却的营养肉汤培养基3份,每份100ml,一份加入相应稀释级别的规定量的供试液,作为供试品;一份加入相应稀释级别的规定量的供试液以后,再加入1ml对照菌液(含菌量10-100cfu/ml)作为阳性对照;还有一份加入与供试液等量的稀释液,作为阴性对照。于30-35℃培养18~24h。取上述培养物0.2ml接种于5mlMUG培养基中。
实验后:
1.清洁及卫生:做完实验后,用消毒液对操作台面及地面进行擦拭消毒,用紫外灯照射超净工作台30分钟。用洗衣粉刷洗玻璃器具后,再用纯化水进行润洗2-3次,烘干(若是受污染的玻璃仪器应该用铬酸洗液浸泡后再行清洗)。需要清洗的洁净服应及时传出清洗。
2.培养及结果观察:细菌的平板应在30-35℃下培养3天,霉菌应在23-38℃下培养5天,控制菌应在30-35℃下培养18-24小时。阴性及空白对照应无菌生长。控制菌的阳性对照平板上所生长的菌落应与描述相符。若控制菌平板上不长菌则判定为未检出,若长出疑似金色葡萄球菌进行血浆凝固酶实验,若长出疑似铜绿假单胞菌则应进一步进行氧化酶实验及绿脓菌素实验。
检查大肠埃希菌的MUG培养基在5小时、24小时在366nm的紫外线下进行观察,并用未接种的MUG培养基培养基做本底对照,还应加入靛基质观察颜色是否生成玫瑰红色。若MUG阳性、靛基质阳性判定检出大肠埃希菌,MUG阴性、靛基质阴性判定未检出大肠埃希菌,若MUG阴性、靛基质阳性或者MUG阳性、靛基质阴性则应再接种乳糖胆盐培养基的培养物于麦康凯琼脂培养基或曙红亚甲蓝琼脂培养基的平板,30-35℃培养18-24小时,并进行观察,未长出菌落或菌落于描述不符,则判定未检出大肠埃希菌,若长出的菌落于描述相符,判定检出大肠埃希菌。
3.填写记录和报告:各个记录,台账应及时填写。出具报告时,若检出控制菌或其他致病菌时,按一次检出结果为准,不再复试;霉菌和酵母菌数其中任何一项不符和该品种项下的规定,应从同一批样品中随机抽样,独立复试两次,以3次结果的平均值报告菌数;细菌、霉菌和酵母菌数及控制菌的检查结果均符合规定,判定合格;若其中任何一项不符规定,判定供试品不合格。